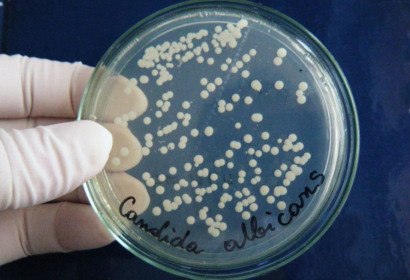

Инфекционным заболеванием, которое развивается в результате активного размножения дрожжеподобных грибов рода Кандида, является молочница (кандидоз). Свое название болезнь получила из-за характерных признаков: белый налет во рту у ребенка, по внешнему виду напоминающий молоко. Чаще поражает малышей до года по причине наличия у них ослабленного (несформированного) иммунитета.
Возбудитель инфекции
Молочницу у ребенка вызывает целая группа дрожжеподобных грибов: Candida krusei, Candida albicans, Candida tropicalis и др. Они обитают не только в окружающей среде, но и во рту, кишечнике. Наличие сильного иммунитета служит преградой для размножения бактерий, поэтому у здорового человека молочница отсутствует. И, при наличии благоприятных условий в организме (повышение pH слизистой оболочки, снижение иммунитета, наличие сопутствующих заболеваний: сахарный диабет, эндокринные нарушения) бактерии начинают активно размножаться, вызывая кандидоз.
Причины развития молочницы во рту
- недостаточно промытые, продезинфицированные соски, посуда для кормления ребенка, игрушки;
- заболевания желудочно-кишечного тракта (в частности, дисбактериоз);
- частые простуды, ОРЗ, на фоне которых еще больше ослабляется иммунитет;
- несоблюдение матерью гигиены (например, наличие бактерий на молочных железах при недостатке водных процедур или приготовление молочной смеси для ребенка грязными руками);
- кормление малыша смесью с большим содержанием сахара, что создает благоприятную среду для размножения бактерий;
- наличие аллергического дерматита у грудничка;
- длительный прием антибиотиков, гормональных препаратов;
- частые срыгивания после кормления (частички пищи остаются во рту и вызывают гнилостные процессы);
- наличие молочницы на руках, ногтях у матери;
- хронические заболевания у малыша (сахарный диабет);
- недостаток в рационе витаминов группы В, а также аскорбиновой или никотиновой кислот.
У детей дошкольного и школьного возраста молочница может развиться из-за употребления непромытых овощей, фруктов (в т. ч. при употреблении еды грязными руками). Также причиной могут стать чистка зубов чужой щеткой, употребление в пищу продуктов животного происхождения (молоко, плохо прожаренное мясо).
Особенно высок риск возникновения молочницы у недоношенного ребенка, а также при наличии у матери туберкулеза или ВИЧ-инфекции.
Характерные симптомы и этапы развития молочницы

- легкая — характеризуется появлением во рту небольших красных пятнышек или язвочек, которые со временем покрываются плотным белым налетом. На слизистой оболочке рта образуется белая пленка и при попытке ее убрать может открыться небольшое кровотечение в ротовой полости.
- Средняя стадия кандидоза — вся полость рта заполняется творожистым белым налетом, под которым образуются болезненные, кровоточащие язвы. Ребенку больно сосать и глотать, поэтому он отказывается от пищи. Происходит потеря чувства вкуса, на языке появляется еще более плотный налет, а в уголках рта возникают мелкие трещины.
- Тяжелая стадия молочницы — язвочки во рту сильно кровоточат, налет появляется на деснах, небе и внутренней стороне щек. Полость полностью покрыта белой пленкой и малыш испытывает интенсивную боль. На этой стадии его общее самочувствие заметно ухудшается, а температура тела повышается до 37-38°C.
С легкой стадией можно справиться в домашних условиях. А при средней или тяжелой не обойтись без помощи медиков.
Формы болезни
Специалисты выделяют две формы молочницы у детей: острую и хроническую. И каждая из них характеризуется отличными друг от друга симптомами.
Для острой формы характерна сухость во рту и плотный белый или желтоватый налет, который состоит из бактерий, эпителиальных клеток, остатков пищи. Со временем он становится больше, а в уголках губ появляются трещины, покрытые белой пленкой. Кандидоз протекает с увеличением шейных лимфоузлов, сильной болью, чувством жжения во рту, повышением температуры тела.
Острую форму болезни часто путают с ангиной, стоматитом, дифтерией. Поэтому для определения точного диагноза необходимо сдать анализы.
Для хронической формы молочницы у грудничка характерен желтый или коричневый налет на слизистой оболочке ротовой полости, а также на языке, внутренней стороне щек. Могут наблюдаться увеличение шейных лимфоузлов и отеки в полости рта. Имеющуюся пленку самостоятельно убрать невозможно: при каждой попытке это сделать слизистая и язвочки будут кровоточить, вызывая болезненные ощущения, дискомфорт.
Данная форма болезни подразумевает длительное лечение, поэтому лучше не доводить малыша до такого состояния и своевременно обращаться к врачу.
Диагностика

- Сдать мазок изо рта. Небольшое количество налета из ротовой полости наносят на специальное стекло и высушивают. Далее врач с помощью микроскопа выполняет осмотр и устанавливает точный диагноз.
- Общий анализ крови. Поможет определить степень интоксикации в организме.
- Общий анализ мочи. Сдается для определения уровня глюкозы.
- Сделать иммунограмму. Комплексный анализ для оценки состояния иммунной системы.
В большинстве случаев бывает достаточно одного мазка из ротовой полости, чтобы выявить кандидоз у ребенка.
Возможные осложнения
Развитие осложнений возможно в том случае, если молочница перешла в хроническую форму:
- нарушение работы органов дыхания (в частности, развивается астма, бронхит), поскольку грибковая инфекция постепенно переходит из ротовой полости на ближайшие по соседству органы;
- обезвоживание и истощение организма;
- сильное ослабление иммунной системы, что приводит к развитию других инфекционных заболеваний;
- заболевания лор-органов (ринит, отит);
- повреждение слизистой оболочки пищевода, желудка;
- ухудшение аппетита, приводящее к снижению массы тела;
- повышенная нервозность, нарушение сна;
- сепсис (распространение инфекции с кровотоком по всему организму).
Своевременное обращение к врачу поможет избежать осложнений и предупредить развитие хронической формы молочницы у грудничка.
Тактика лечения
Терапия начинается с устранения возможности распространения инфекции. На начальной стадии болезни у новорожденного лечение обычно не требуется. Необходимо просто облегчить его состояние (поддерживать чистоту в помещении и оптимальную влажность воздуха — 70%, регулярно проветривать комнату). При нормальном состоянии слизистых оболочек и отсутствии благоприятных условий для размножения бактерий, состояние малыша в скором времени нормализуется.
Детям старше года потребуется обработка рта от налета:
- стерильный марлевый тампон смочить в содовом растворе (1 ч. л. на 1 л кипяченой воды);
- аккуратно обработать ребенку ротовую полость (процедуру повторять несколько раз в день до улучшения состояния).

- Раствор Люголя — 1-2 раза в сутки смазывают слизистую оболочку глотки и гортани (с помощью ватного или марлевого тампона). Терапию проводят до полного выздоровления.
- Фенистил-гель — смазывают слизистую оболочку ротовой полости 2-4 раза в сутки. Средство используется для устранения сильного зуда.
- Нистатин (противогрибковый антибиотик) — измельчить таблетку в порошок и перемешать с 2 ч. л. теплой кипяченой воды, полученным раствором обрабатывать полость рта (2-3 раза в день). Средство обладает противовоспалительным, обезболивающим действием, и подходит даже грудничкам.
- Кандид (1% раствор для местного применения) — несколько капель средства наносят на пораженные участки полости рта (3-4 раза в день), используя для этой цели ватную палочку. Терапию проводят до полного устранения симптомов. Препарат оказывает губительное действие на клетки бактерий и замедляет рост патогенной микрофлоры, постепенно избавляя от налета.
- Мирамистин — небольшой ватный тампон смачивают в лекарственном растворе и обрабатывают слизистую оболочку полости рта. Процедуру проводят несколько раз в день (до полного выздоровления).
Указанные средства представлены исключительно в ознакомительных целях. По вопросам лечения следует обратиться к педиатру за консультацией.
Профилактические мероприятия
Можно избежать появления молочницы у ребенка. Для этого необходимо соблюдать ряд несложных профилактических правил:
- поддерживать гигиену кормящей матери (обмывать молочные железы перед каждым кормлением, мыть руки с дезинфицирующим мылом);
- регулярно обрабатывать детскую посуду (бутылки, кружки), игрушки, соски (для очищения можно использовать содовый раствор, кипячение);
- не позволять ребенку пользоваться чужими предметами личной гигиены (особенно зубной щеткой);
- по возможности кормить малыша грудным молоком;
- следить, чтобы ребенок не ел грязными руками;
- укреплять иммунитет малыша.
Молочница — тяжелое болезненное состояние, причиняющее малышу сильный дискомфорт. Поэтому при обнаружении первых симптомов заболевания необходимо скорее показать его врачу. Он проведет ряд диагностических процедур и назначит лечение. Только своевременная терапия поможет избежать возможных осложнений и предупредит хроническую форму болезни.
В возрасте же до года оно возникает чаще всего из-за вынужденного приема ребенком или его кормящей матерью антибиотиков, а у новорожденных – при прохождении в родах через колонизированные Кандидами родовые пути.
О возбудителе
Когда для микроба Кандиды создаются благоприятные условия, он активно размножается, образуя длинные цепочки клеток со слабой связью между ними – псевдомицелий. Эта структура, а также разрушенные клетки слизистой, остатки пищи и вещества под названием фибрин и кератин – и есть тот белый налет, который обнаруживается на слизистых оболочках при молочнице.
Размножившись в достаточном количестве, микробы приобретают способность распространяться вдоль здоровых тканей – кожи и слизистых оболочек. Так, осложнением нелеченной молочницы полости рта может стать поражение глотки, пищевода и других внутренних органов. Грибок может попадать и в кровь, вызывая заражение крови – сепсис.
Причины заболевания
Молочница у ребенка в полости рта возникает при попадании грибка на его слизистые оболочки:
Особенно высок шанс заразиться у недоношенных детей, детей, рожденных от матерей, больных туберкулезом, ВИЧ-инфекцией.
- при кормлении грудью или из бутылочки, на которых находится Кандида;
- если происходит контакт ребенка и молодых домашних животных или птицы;
- если человек, который ухаживает за ребенком, производит также уход за молодыми телятами, жеребятами, птицами или щенками, и при этом не моет руки;
- если человек, ухаживающий за младенцем, имеет кандидозные заболевания рук или ногтей;
- если родители или родственники ребенка не моют руки после работы с сырым мясом, молочными продуктами, овощами или фруктами;
- не кипятят упавшую соску;
- ребенок получает антибиотики или подвергается химиотерапии или лучевому лечению;
- когда ребенок часто срыгивает, и еда не убирается из его полости рта.
Особенно высок шанс возникновения у недоношенных детей, тех, чьи матери больны туберкулезом, ВИЧ-инфекцией.
Основные причины – такие же, как и у детей до года.
Также дети до года заболевают, когда:
- начинают брать в рот немытые овощи, фрукты, игрушки;
- дети постоянно играют с домашними или сельскохозяйственными животными, и тянут в рот продукты или игрушки, которые находятся там же, где и животные;
- если ребенок получает антибиотики, гормоны-глюкокортикоиды;
- когда малыш вынужден получать химиотерапию или лучевую терапию;
- если у него неправильно растут зубы и они травмируют слизистую рта;
- когда в питании недостаточно витаминов группы B, C или PP;
- ребенок пытается чистить зубы зубной щеткой взрослых;
- из-за кишечных заболеваний;
- молочница может быть первым симптомом сахарного диабета или лейкоза.
Причины такие же, как и у детей до года. Добавляются также:
- употребление сырого молока или мяса;
- когда в рационе – немытые овощи и фрукты;
- если ребенок играет с домашними животными, потом не моет руки, которыми ест.
Молочница во рту таких детей может быть первым признаком:
- сахарного диабета;
- лейкоза (рака крови);
- иммунодефицита (не обязательно вследствие ВИЧ, могут быть и другие, в том числе и врожденные иммунодефициты);
- эндокринных болезней (в основном, когда поражается кора надпочечников).
Дисбактериоз вследствие неправильного питания, приема антибиотиков, курение и употребление наркотиков или алкоголя (это бывает у подростков), прием оральных контрацептивов увеличивают шанс заболеть.
Молочница у грудного ребенка появляется очень часто – до года 5-20% детей переносят это заболевание, некоторые – неоднократно. Это объясняется тем, что иммунитет слизистых оболочек рта у таких малышей еще не сформирован, микрофлора, живущая там, подвержена частым изменениям. Да и сам эпителий, из которого выполнена поверхность полости рта, еще не до конца сформирован. Поэтому возникающая до года молочница – это не повод для паники.
Как вовремя увидеть молочницу
По первым симптомам молочницу у детей во рту распознать крайне трудно: это покраснение и отечность, которые могут появляться на нёбе, миндалинах, деснах, языке и внутренней стороне щек. Далее на красном блестящем фоне слизистой оболочки, которая уже начинает болеть и зудеть, появляются крупинки белого цвета, похожие на манную крупу. Их можно легко снять ложкой.
Следующим этапом будет увеличение налета, который уже становится похож на остатки творога во рту (реже – имеет сероватый или желтоватый оттенок). Если их снять тупым предметом (ложкой, шпателем), под ними будет видна красная блестящая поверхность, на которой, если вы сильно скоблили, появляются капельки крови, напоминающие росу. Изменение слизистой оболочки сопровождается болью и жжением во рту. Они усиливаются во время глотания пищи и употребления пищи, особенно если она острая, горячая или кислая. Присутствует во рту и металлический вкус. Из-за этого ребенок плачет и отказывается от еды. При отсутствии лечения и на этой стадии, или если иммунитет ребенка сильно подавлен, белые пленки распространяются все дальше, повышается температура тела, нарушается сон, грудной ребенок может часто срыгивать и прекратить набирать вес.
Иногда молочница у детей выглядит как заеда – трещина в углу рта. Она отличается от заед, образованных при дефиците витамина A тем, что вокруг трещины имеется покраснение, а сама она покрывается белесым налетом. Кандидозная заеда редко сопровождается повышением температуры или ухудшением общего состояния, но она делает открывание рта болезненным. Эта форма молочницы наблюдается чаще у детей, которые сосут пустышку или палец.
Таким образом, родители грудных младенцев должны насторожиться и осмотреть рот ребенка, если он:
- плачет, когда берет в рот соску или грудь;
- отказывается от груди;
- капризен, у него отмечается повышенная температура без соплей и кашля.
Степени тяжести молочницы полости рта
После покраснения больших участков слизистой оболочки, на что ребенок реагирует беспокойством и плачем, на них появляются творожистые налеты. Эти налеты появляются и на языке, и на слизистой оболочке щек, и на деснах, и даже переходят на губы и горло – создается вид одной большой белой пленки.
Как поставить диагноз
Конечно, вы можете заподозрить молочницу, когда сравните проявления, видимые во рту собственного ребенка, с картинками, где показаны проявления этого заболевания. Но педиатр или ЛОР-врач, поставят точный диагноз. Правда, и он требует подтверждения в виде посева налета, взятого изо рта. Дело в том, что Кандид несколько, и не каждая из них поддается стандартной терапии. Тогда в случае, если первично назначенное лечение не поможет, на основании бакпосева и определения чувствительности гриба к противогрибковым препаратам, врач сможет назначить обоснованное лечение, которое подходит для ребенка этого возраста.
Сдача бакпосева производится натощак, до того, как ребенок попьет воду или почистит зубы.
В диагностике может понадобиться такая методика исследования, как непрямая ларингоскопия, которую проводит ЛОР-врач. Она нужна для того, чтобы понять, насколько глубоко распространяется поражение – захватывает глотку и гортань, или нет. Это требует особых усилий родителей, врача и его помощника.
Также для диагностики важны:
- общий анализ крови: он покажет уровень воспаления и вовлеченность организма в этот процесс, по этому анализу можно заподозрить лейкоз;
- глюкоза крови (так как молочница – маркер сахарного диабета);
- иммунограмма – во время болезни, а также через месяц после нее, чтобы оценить активность иммунитета.
Лечение
Сказать, чем лечить молочницу у ребенка во рту, должен или ЛОР-врач, или педиатр: заболевание серьезное, и при этом есть ограничения по препаратам в детском возрасте.
Итак, лечение молочницы у детей во рту начинается с того, что:
Диета для кормящей матери или ребенка старше года:
| Можно | Нельзя |
|
|
- Антибиотики, хоть они вызываю развитие молочницы, отменять самостоятельно нельзя: так можно добиться серьезных осложнений со стороны тех инфекций, на уничтожение которых и было направлено действие антибактериального препарата.
Обработка полости рта – это основа лечения для детей до 6 месяцев, и обязательный компонент лечения для старших детей.
Для детей до 6 месяцев лечение заключается в обработке полости рта:
Если у ребенка повышена температура, или творожистый налет распространяется быстро, возьмите свой 1% раствор соды, и обращайтесь для госпитализации в стационар: там ребенку окажут необходимую для поддержания его состояния помощь.
Если вследствие поражения слизистой рта ребенок отказывается есть и пить, обращение в стационар – обязательно. Голодание и отсутствие поступления в организм жидкости лечебным быть не может.
Для проведения обработки нужны:
Вначале родитель моет руки. Затем он распечатывает марлю, наматывает ее на свой указательный палец, макает его в стакан с водой и аккуратно освобождает рот от налетов. Далее нужно выбросить эту марлю, взять новую, и повторить ту же манипуляцию с содовым раствором или антисептиком.
Профилактика заболевания
Она заключается в соблюдении следующих мероприятий:
- кипячение сосок и бутылочек;
- мытье груди перед кормлением;
- обработка игрушек;
- лечение молочницы во время беременности;
- своевременное употребление молочнокислых бактерий при лечении антибиотиками и гормональными препаратами;
- ограничение доступа к ребенку людям, имеющим заболевания ротовой полости, рук и ногтей;
- ранняя чистка зубов с помощью кипяченой воды и специальных щеточек;
- своевременное, но не раннее введение прикорма, оптимально – из свежих овощей, фруктов и кисломолочных продуктов.
Причины возникновения
Важно понимать, что причины возникновения кандидоза варьируются в зависимости от возраста. Молочница у ребенка во рту до года легко поддается терапии и возникает у каждого 5 ребенка. В более позднем возрасте признаки болезни могут говорить о серьезных патологиях. Соответственно, если в недавнем времени не проводилась антибиотикотерапия, рекомендуется скорейшее обследование.
Микрофлора во рту у грудного ребенка подвержена частым изменениям, а эпителий слизистой еще не до конца сформировался. Это является благоприятными условиями для размножения дрожжеподобного грибка.
Причины появления болезни у детей в 1 месяц жизни:
- Внутриутробное заражение через плаценту или во время прохождения через родовые пути, если мать страдает генитальным кандидозом.
- Заражение во время кормления, если инфицирован сосок.
- Передача патогенных бактерий через руки человека, страдающего одной из форм молочницы.
- Прием антибиотиков кормящей матерью может снизить иммунитет ребенка, так как лекарственные вещества, как правило, попадают в организм младенца с молоком.
- Постоянные срыгивания или рвота приводят к тому, что в ротовой полости остаются остатки молока, создающие благоприятную среду для размножения грибка.
У детей от 1 месяца до 1 года причинами появления молочницы могут быть также факторы, описанные выше, но к ним прибавляются и следующие:
- Грязные соски бутылочек и пустышек. Candida может попасть на руки ребенка, свободно ползающего по квартире, с плохо вымытого пола. Малыш тянет грязные кулачки в рот, и заражается бактериями.
- Сухой воздух в комнате и недостаточное питье приводит к недостатку слюны, которая обладает защитными свойствами от различного рода патогенных микроорганизмов.
- Простудные вирусные заболевания, аллергический дерматит, необходимость антибиотикотерапии могут повлиять на появление молочницы во рту ребенка.
- Дети на искусственном вскармливании заражаются чаще, так как не получают с молоком матери необходимых веществ, защищающих организм от разных болячек.
Дети до 3 лет могут заразиться молочницей вдобавок из-за:
- Грязных фруктов или овощей, воды из-под крана, сырого молока;
- Вдыхания пыли;
- Плохо помытой посуды, использования зубной щетки взрослого человека;
- Недостатка витаминов;
- Инфекций ротовой полости и травм слизистой в случае неправильного роста зубов;
- Заболеваний ЖКТ.
Молочница в этом возрасте может свидетельствовать о возможном развитии эндокринных заболевания или онкопатологий крови.
В более старшем возрасте кандидоз во рту у ребенка возникает еще и вследствие неправильного питания. У подростков молочница во рту может появиться из-за гормональных перепадов и частого переохлаждения.
Курение, употребление алкоголя или наркотиков, оральные контрацептивы также могут спровоцировать развитие болезни.
Как выглядит молочница у ребенка во рту: симптомы и фото
Общие признаки, при которых следует насторожиться и осмотреть ротовую полость ребенка:
- Нежелание есть;
- Остановка или снижение набора веса;
- Беспокойный сон;
- Постоянные срыгивания;
- Жалобы ребенка на дискомфорт во рту и в горле.
Болезнь может протекать по-разному. Легкая форма поддается быстрому излечению и характеризуется:
Средняя тяжесть протекания молочницы выражается в:
- Творожистоподобных бляшках, которые постепенно сливаются и поражают всю слизистую;
- Наличии кровоточащих язвочек;
- Большом пласте налета на языке;
- Трещинках в уголках рта;
- Отказе от еды и частом плаче.
При тяжелом течении заболевание поражает большую область. На фото молочницы у детей во рту, в горле и на губах отчетливо различим серый или желтоватый налет.
Отмечаются следующие признаки:
- Повышение температуры тела, иногда до 39 градусов;
- Общая вялость;
- Полное отсутствие аппетита;
- Сильная болезненность.
В этом случае необходимо принимать скорейшие меры: запущенный кандидоз может привести к инфекциям дыхательных путей и проникновению грибка в пищеварительную систему ребенка.
Лечение молочницы у детей во рту
Крайне важно вовремя начать терапию, если возникла молочница у ребенка во рту. Чем лечить заболевание может решить только врач-педиатр.
Помимо приема медикаментозных препаратов, необходимо тщательно соблюдать правила личной гигиеной, стерилизовать все предметы, с которыми взаимодействует ребенок. Для взрослых также рекомендована противогрибковая терапия, чтобы исключить риск повторного заражения.
И рацион питания требует коррекции. Кормящей матери или ребенку необходимо питаться овощами, несладкими фруктами, нежирным мясом или рыбой, гречкой, вареными яйцами.
Полностью исключаются: кофе и черный чай, сладкие и сдобные продукты; молоко, грибы.
Терапия и подбор лекарств всегда зависят от остроты протекания болезни и возрастных особенностей.
Для детей с первого дня рождения и до полугода лечение заключается в местной обработке полости рта раствором соды (1 чайная ложка на 1 л воды). Противогрибковые лекарства назначаются в редких случаях.
После 6 месяцев лечение молочницы во рту может включать использование таких препаратов, как:
- Кандид. Лекарственный раствор, которым необходимо обрабатывать полость рта 3-4 раза в день.
- Фуцис ДТ. Таблетки, которые необходимо растворить в воде, и полученной жидкостью смазывать пораженные места. Дозировка назначается педиатром.
- Мирамистин. Антибактериальный препарат, продающийся в форме мази или раствора. Применяется для обработки участков слизистой, покрытых налетом, и трещин на губах.
- Флуконазол, Дифлюкан. Медикаменты для системного лечения в случае острого протекания заболевания. Необходимая доза препарата зависит от веса ребенка.
Терапия кандидоза у детей старше года включает медикаментозные средства, описанные выше. К ним могут добавиться:
- Феррум-Лек. Сироп, содержащий железо.
- Фенистил. Антигистаминный гель, который необходимо наносить на кожу вокруг рта при сильном зуде.
- Гексорал. Спрей с антисептическим действием для обработки рта. Назначается только после 3 лет.
- Раствор Люголя. Рекомендуется в случае отсутствия аллергических реакций на йод. Применяется для смазывания трещин на губах.
- Витамины группы В.
- Нистатиновая мазь. Целесообразно использовать не ранее, чем в 12 лет. Служит для обработки кожных покровов.
Лечение народными методами допустимо в случае легкого течения заболевания. Самые распространенные средства:
- Настои и отвары трав (зверобой, шалфей, ромашка, эвкалипт, календула). Применяются для полоскания в старшем возрасте или для обработки ротовой полости у малышей.
- Сок алоэ. Обладает заживляющими свойствами, но очень горчит. По этой причине больше подходит для детей от двух лет. Для использования необходимо разводить в воде.
- Облепиховое масло. Эффективно в комплексе с травяными настоями. После полоскания или обработки полости рта следует смазать им пораженные области.
Основной причиной появления такого заболевания, как молочница во рту у ребенка, Комаровский считает нарушение защитных функций слюны. С его точки зрения, можно говорить о развитии болезни, если образуется налет не только на языке, но и на внутренней стороне щек.
Основные принципы лечения:
- Необходимо регулярно поить ребенка, особенно после кормления;
- Поддерживать в комнате оптимальные условия – температуру около 20 градусов и влажность не менее 50%;
- Своевременно очищать носовые проходы, чтобы ребенок не дышал ртом;
- Часто гулять и не перегревать младенца;
- Не допускать продолжительного плача – из-за этого пересыхает слизистая рта.
Все эти меры помогут нормализовать необходимые свойства слюны, что приведет к излечению болезни. В крайнем случае, можно обрабатывать полость рта раствором пищевой соды.
Профилактика детского кандидоза
Меры профилактики детской молочницы заключаются в:
- Своевременном лечении матери от вагинального кандидоза;
- Стерилизации сосок и бутылочек, обработке игрушек;
- Соблюдении матерью правил личной гигиены;
- Раннем приучении к чистке зубов;
- Исключении контактов с людьми, имеющими грибковые заболевания;
- Приеме лактобактерий во время антибиотикотерапии;
- Введении прикорма, который содержит в составе кефир, творожки, овощи и фрукты;
- Тщательном контроле общего состояния здоровья малыша.
Читайте также:
